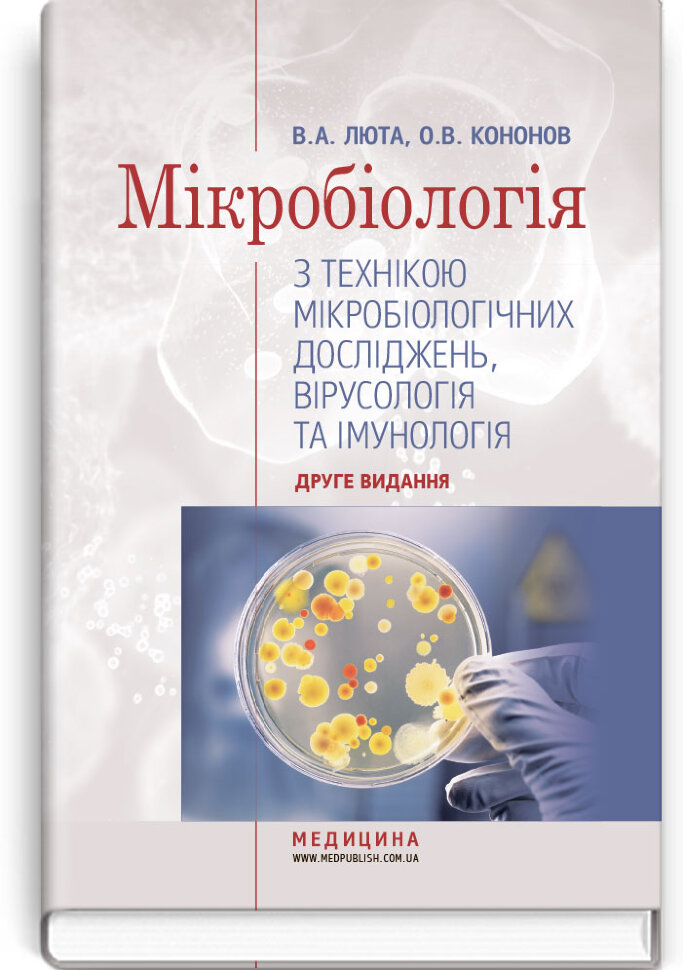
Мікробіологія з технікою мікробіологічних досліджень, вірусологія та імунологія: підручник (ВНЗ І—ІІІ р. а.). Автор — В.А Люта, О.В Кононов. Обложка — тверда

Отвечаем на звонки
Пн-ПТ: 10:00-18:00
Сб-Нд: Вихідний
Мікробіологія з технікою мікробіологічних досліджень, вірусологія та імунологія: підручник (ВНЗ І—ІІІ р. а.)
В.А Люта, О.В КононовКод: 15470Характеристики
- Автор
- В.А Люта, О.В Кононов
- Издательство
- ВСВ «Медицина»

- Обложка
- тверда
- Формат страниц
- 70х100/16
- Тип издания
- підручник
- Язык
- Украинский
- Издание
- друге видання
- Год издания
- 2018
- ISBN
- 978-617-505-702-5
- EAN-13
- 9786175057025
- Иллюстрации
- чорно-білі
- Кол-во страниц
- 576
- Тип
- Бумажная книга
О книге
У підручнику на сучасному науковому рівні описано властивості основних збудників інфекційних захворювань, особливості епідеміології, патогенезу і клінічної картини цих захворювань, механізму формування патологічних процесів та імунологічних реакцій з боку макроорганізму, а також відбору патологічного матеріалу та умови транспортування. Особливу увагу приділено методам лабораторної діагностики, які описано з урахуванням методичних вказівок та інструкцій, затверджених наказами МОЗ України, а також Державних санітарних норм і правил.
Для студентів медичних навчальних закладів — училищ, коледжів та інститутів медсестринства зі спеціальностей «Лабораторна справа», «Медико-профілактична справа», «Сестринська справа», «Лікувальна справа», «Акушерська справа»
Свернуть